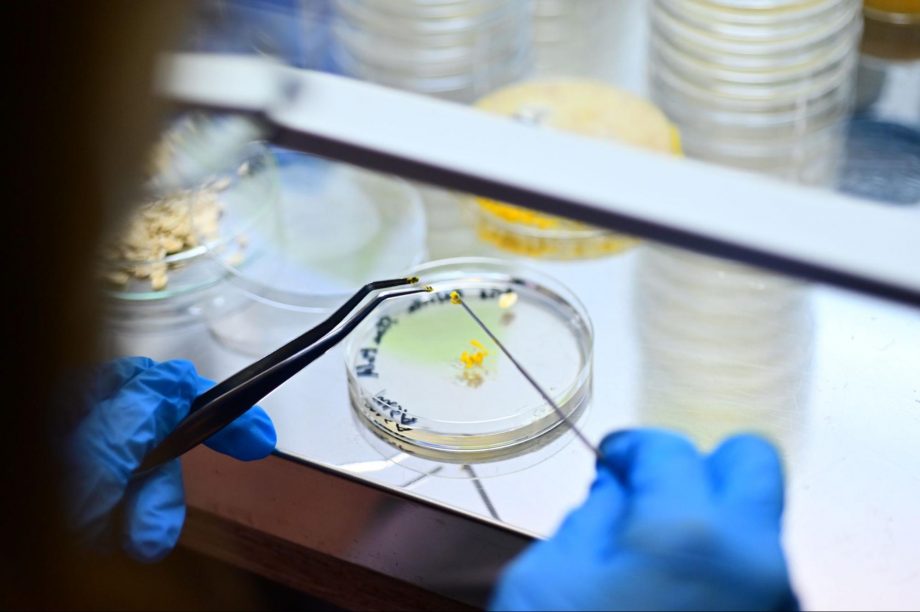

Event report
2022.9.5
浦野 奈美
SPCS / FabCafe Kyoto
BioHack Academyは、市民がバイオテクノロジーを学ぶ3ヶ月間の集中プログラム。オランダのアムステルダムにあるWaagを起点とし、世界数カ所で毎年同時開催されている、グローバルな分散型コースです。FabCafe MTRLで活動を展開するBioClubは、バイオアーティストのゲオアグ・トレメルのもと、過去6回にわたって公式パートナーとしてBHAを開催してきました。BioClubでの開催としては3年ぶりとなった2022年のBHAでは、普段さまざまな領域で活動する7名が参加しました。本記事では、BioHack Academy 2022の概要と活動内容を紹介します。(参考:BioHack Academy BioClubの概要)
たとえば、30年前はヒトのゲノムを読むのに3000億円かかっていたのが今は10万円以下のコストでできるようになっているように、バイオテクノロジーは私たち市民が個人単位で向き合い、それぞれの活動に取り込んでいくことができるものになっています。生物学の応用と自然を基盤とした解決策を形作るために、あるいは、もっと個人的な疑問に向き合うために、専門家以外の市民も知識や技術を身につける環境ができてきています。そこで、BioClubは、オランダのWaagが主催するバイオテクノロジーを公共化する分散型の学習プログラム「BioHack Academy(以下、BHA)」の公式パートナーとして、過去6回にわたって毎年プログラムを開催してきました。
BHAでは、生物学とバイオテクノロジーの基礎、DIYバイオラボとオープンソースハードウェアの作り方、バイオマテリアルの扱い方、実験の設計と実施方法などを適切な安全基準に基づいて学ぶことができ、自分で製作したオープンソースのハードウェアのみを使用して、独自のバイオマテリアルを設計、成長、抽出する方法を学びます。

本プログラムはバイオテクノロジーを市民に開くことが目的なので、生物学に関する専門知識は不要です。2022年も多種多様な領域から7名の受講者が参加(半数以上はバイオに触れたことのないメンバー)。それぞれのバックグラウンドも生かしながら、バイオの世界を探究しました。(受講者の声は記事最下部を参照)
プログラムとしては、毎週月曜の夜にZoomでオランダと繋いで実施されるグローバルレクチャーのほか、BioClubのゲオアグ・トレメルのディレクションによる日本の専門家からのレクチャーが毎週火曜に、そのほかの平日にはBioClubで実験活動が実施されました。さらに不定期で関東近郊の研究室や展示会などへのフィールドワークが企画されるなど、かなり濃い内容。基礎知識を学びながら、参加者それぞれのファイナルプロジェクトの制作を行い、6月4日にはゲストを招いて作品展示とプレゼンテーションを行いました。

BHAを主導するWaagは、オランダのアムステルダムにある研究・教育機関です。前提として「テクノロジーは中立ではない」と定義したうえで、あらゆるテクノロジーを専門家以外の市民に開くことで、領域横断の学びや社会実践を推進するとともに、市民全体のテクノロジーリテラシーを高めることをミッションとして活動しています。したがって、Waagの研究やプログラムを企画・運営するメンバーも、研究者・アーティスト・デザイナーが共同で進めています。バイオテクノロジーも彼らがメインで扱うテーマのひとつ。「Hybrid Lab Network」という取り組みの中でBHAも実施され、他大学や世界のパートナーと共同しながら、分散型のラボプログラムや公開討論、ワークショップなどを行い、批判的・創造的思考の醸成とイノベーション促進に向けて、柔軟なカリキュラムの開発に取り組んでいます。

アカデミック/ハッカー/バイオデザイン/バイオアートについて、各分野の実践者の講義を受けながら学びます。主なプログラムは、毎週月曜のWaagのレクチャー、火曜の夜の日本の専門家によるレクチャー、そして木曜の午後の実習ですが、不定期でバクテリア収集やハードウェア制作のための部品収集、バイオに関連する展示や研究室への訪問など、任意参加のフィールドワークも実施されました。
1週目:イントロダクション
- レクチャー(Waag)
- バイオハッキングとは何か(Lucas Evers)
- 実験のドキュメンテーションの方法(Kas Houthuijs and Maarten Smith)
- 創作活動としてのバイオハッキング(Ionat Zurr)
- ラボとバイオセイフティについて(Kas Houthuijs and Per Staugaard)
- レクチャー(BioClub)
- バイオインフォマティクス・希少疾患領域(Tiago Lopes)
- 実習(BioClub)
- ドキュメンテーション(Markdown, WordPress, GitHub, Notion)

2週目:ラボの解体
- レクチャー(Waag)
- ラボのハードウェアについて(Kas Houthuijs and Maarten Smith)
- 「ラボ」とは何か?(Kas Houthuijs and Maarten Smith)
- 再現性について(Paul Vanouse)
- 分光器の分解(Maarten Smith)
- USBスペクトロメーターの組み立て(Maarten Smith)
- 実習(BioClub)
- ハードウェアの解体と構築(Foldscope, PocketPCR, 分光器)

ポケットPCRを組み立てている様子
3週目:ラボの構築
- レクチャー(Waag)
- DIYのラボをつくる (Urs Gaudenzlink)
- ファブラボとは(Kas Houthuijs and Maarten Smith)
- オープンソースのデジタルデザイン(Maarten Smith)
- オープンソースメイキング(Kas Houthuijs and Maarten Smith)
- 既存の実験用ハードウェアの分解
- オープンソースの設計図を使って実験用ハードウェアを自作する
- レクチャー(BioClub)
- シアノバクテリアとバイオ/メディア/アート(岩崎秀雄)
- 実習(BioClub)
- クリーンベンチの制作、3Dデザイン

自由な発想でクリーンベンチの構造を考え、たまたま実験していたBioClubメンバーに実際に試作品を使ってもらう。
第4週:マテリアルを育てる
- レクチャー(Waag)
- 地衣類を用いたバイオアートリサーチ(LichenAdriana Knouf)
- バイオの基礎(Kas Houthuijslink)
- ラボのバイオセーフティについて(Kas Houthuijs and Per Staugaard)
- バイオマテリアル(Margherita Soldati、Lorena Trebbi)
- レクチャー(BioClub)
- DNA Music & Yeast(酒井真由美)
- パーソナルバイオリサーチとYCAMバイオリサーチについて(津田和俊、伊藤隆之)
- 実習(BioClub)
- 培地の作成とバクテリアの培養
- 秋葉原で実験道具作成のための部品収集(フィールドワーク)
-

粘菌の培養を試みている様子。
-

ツールをつくるために必要な部品を探しに秋葉原へ。
第5週:遺伝子組み換え
- レクチャー(Waag)
- クリエイティブな遺伝子組み換え生物(GMO)(Lucas Evers)
- GMOの基礎(Kas Houthuijs)
- GMOを育てる(Kas Houthuijs)
- デザインフィクションの課題(Frank Vloet)
- 芸術的実践としての合成生物学(Howard Boland)
- タンパク質の分離(Kas Houthuijs)
- レクチャー(BioClub)
- バイオハッカーとは何か?(増田 展大、城 一裕)
- 実習(BioClub)
- オープンソース分光器の製作
- 早稲田大学岩崎研究室への訪問(フィールドワーク)

メインプログラム以外にも不定期でフィールドワークに行ったメンバーたち。写真はmetaPhorest(早稲田大学生命美学プラットフォーム)を主宰する岩崎研究室への見学の様子。
第6週:コンピュータ上の生命
- レクチャー(Waag)
- 芸術的な文脈におけるCRISPR研究(John La Cava)
- デジタル上のDNAデザイン(Fábio Júnio Ferreira)
- デジタルのDNAデータベース
- DNAデザイン
- 実習(BioClub)
- イーストグラム
- モルトアガート(MA)培地の作成
- カルチャーボックスの作成
- PowerLEDのテスト
- 球体化の実験

紫外線に弱いイースト菌の性質を利用して模様や絵を作る「イーストグラム」を作っている様子
第7週:CRISPR-Cas9の活用
- レクチャー(Waag)
- CRISPRアート(Marta de Menezes)
- CRISPRの基礎(Kas Houthuijs)
- sgRNAの合成、精製(Kas Houthuijs)
- CRISPRの試験管切断(Kas Houthuijs)
- ゲルマニウム電気泳動(Kas Houthuijs)
- 実習(BioClub)
- DNA抽出

BioClubのバイオラボで作業するBHAメンバー。
第8週、第9週:個人プロジェクトの制作
参加者7名がそれぞれ学びを生かした作品を制作。そのためのプロトタイピングと検証に集中する期間として活動が行われました。
第10週目:最終発表会
metaPhorest(早稲田大学生命美学プラットフォーム)の岩崎秀雄先生らをゲストとして招き、参加者の作品展示とプレゼンテーションを実施しました。各作品の説明はこちらのページを参照ください。
■ 作品名と各参加者の資料一覧
人工イクラ(広瀬愛/研究員)

菌卜(羽田光佐/アーティスト)

BHAバイオアンプ(川田祐太郎/情報科学芸術大学院大学 [IAMAS]修士課程 メディア表現研究科 専攻)

PCRテルミン(横川 十帆/東京藝術大学 教育研究助手)

イーストトロープ(長谷川紫穂/学芸員)

Fab-Hack顕微鏡(槌屋洋亮/FabAcademy インストラクター)

3R:遠心分離機のResearch/Replicate/Reconstruct(桜木真理子/大学院博士課程・文化人類学専攻)

私はFabCafe MTRLにBioClubができる前の2016年からBioHack Academyを開催してきました。実は、 最初に開催したBHAを利用してBioClubを作ったんです。BHAはDIYやDIWO(Do It With Others)なバイオの世界に飛び込んで学ぶだけでなく、生物学に関わる活動をする国際的なアーティストやデザイナーとつながり、知り合うチャンスでもあります。
私自身がBHAをしていて喜びを感じる時は、たとえば、メンバーが初めてフォールドスコープを覗く、PCRを行う、Bento Labを使う、遺伝子組み換えを行う、ナノポアシーケンスを行う瞬間に居合わせる時です。なぜなら、こうした実験は研究室ではごく一般的で日常的な作業ですが、人々が初めてこれらの新しい世界に触れた瞬間、エンパワーメントと興奮が同時に巻き起こります。そして、それらの知識を持って、生徒たちは自分たちの素晴らしいプロジェクトや実験を行うことができるのです。
BioHack Academyは、生物学、オープンハードウェア、基本的なラボのテクニックの入門コースとして設計されています。受講生はすでに専門家である必要はなく、コース中に必要なすべてを学ぶ機会があります。一方で、デジタルファブリケーション、プログラミング、ラボでの実験など、いずれかの分野のエキスパートであれば、ワークショップやタスクをよりチャレンジングなものに調整することも可能です。学ぶということは、自分のコンフォートゾーンを飛び出し、新しいものに触れること。その時に必要なのは、新しい情報を学び、吸収するための努力と情熱、そして時間です。BHA2022では、専門知識を持ったメンバーと全くの別領域からのメンバーが良い化学反応を生み、それぞれが素晴らしいプロジェクトを完成させました。
BioHack Academyは、バイオラボの技術だけでなく、新たなバイオテクノロジーが私たちの日常生活にもたらす結果や可能性についても学ぶことができます。PCRやCRISPRについて読むのも一つの方法ですが、実際にやってみることで、そのトピックに対する理解や洞察が全く違ってくるはずです。コースについてもっと知りたい方は、私やBHAの参加者たちと気軽に連絡を取ってみてください。

社会人になってからは、やりたいことは迷わずやる人生を送ってきた。BHAに参加し、新しい知識の分野に触れる機会を得て、「やりたいこと」の幅が広がった。一人でコツコツやるのも、コミュニティに参加して取り組むのも両方楽しめるのがDIYバイオの良さだと思った(広瀬愛/研究員)
日本側のホスト役だったゲオルグ・トレメルさんのヒューマニティにも感銘を受けた。バイオに関連した曲しか歌わないカラオケを提案したり、昆布出汁でコンブチャを作ったりと、ゲオルグさんのある種の強引さと、冗談なのか本気なのかわからないユーモアがなければここまで充実した3週間は過ごせなかった。FabCafe MTRLに出入りする方々もみなさんキャラクターの立つ方々で、非常に刺激を受けた。バイオというよりも家庭菜園的な活動ですが、分けていただいたSCOBYでコンブチャを作ったり、学校で粘菌を育て始めている。たまごっちで挫折していた自分にとって、とても大きな前進。(横川 十帆/東京藝術大学 教育研究助手)
私は普段、芸術学の立場からバイオアートやデザインを研究対象としているが、歴史的流れや作品の記述を行なっていても、実はマテリアルのところにどれだけ(自分にとっての)リアリティがあったかな?と振り返るきっかけになった。何らかの形でキッチンバイオの実験やオープン・サイエンス的な学びを続けていきたい。(長谷川紫穂/学芸員)
プログラムが一旦終わった今感じる自分の変化は、他の生物への興味が増したことだと思う。私の部屋にやってくる虫も、歩いてて道に生えている草木も、私と同じATCGでできたDNAを持って、同じ遺伝子コードでここに存在しているんだな、と思うようになった。ラボで微生物培養用の培地を作るとき、培地に入れる栄養素は、私にとってもけっこう良い匂いがして、なんなら美味しそうな時もあった。そういう時に、微生物たちと私は、必要としてる栄養素が同じなんだな、と感じた。そういう他の生物と自分の共通点を知ることに、なんとなく興味が出てきた。(羽田光佐/アーティスト)
DIYの知識とスキルアップを目指して今回参加しました。ファブラボ鎌倉でファブアカデミーというオンラインの授業を終了して「ほぼなんでもつくる」自信はついていたが、その先の世界に行ってみたいと調べていてバイオハックアカデミーを見つけた。自分のファブの知識と今回学んだバイオハックの知識を組み合わせて、DIYでいろいろ試してみたい。(槌屋洋亮/FabAcademy インストラクター)
自分で何かを作る楽しさに目覚めた。何か一つでも自分でできることがあるという気づきが次の目標やモチベーションにつながったので、「興味はあるけど何からすればよいか分からない」という状況から一歩前進できたと感じている。(桜木真理子/大学院博士課程・文化人類学専攻)

BHA2022のメンバーは、2022年9月3日-4日に開催されたMaker Faire Tokyo 2022に参加。コースの中で作った作品を展示/デモンストレーションした。
-
浦野 奈美
SPCS / FabCafe Kyoto
大学卒業後ロフトワークに入社。渋谷オフィスにてビジネスイベントの企画運営や日本企業と海外大学の産学連携のコミュニティ運営を担当。2020年にはFabCafe Kyotoのレジデンスプログラム「COUNTERPOINT」の立ち上げと運営に従事。また、FabCafeのグローバルネットワークの活動の言語化や他拠点連携の土壌醸成にも奔走中。2022年からは、自然のアンコントローラビリティを探究するコミュニティ「SPCS」の立ち上げと企画運営を担当。大学で学んだ社会保障やデンマークのフォルケホイスコーレ、イスラエルのキブツでの生活、そして、かつて料理家の森本桃世さんと共催していた発酵部活などが原体験となって、場の中にカオスをつくることに興味がある。
大学卒業後ロフトワークに入社。渋谷オフィスにてビジネスイベントの企画運営や日本企業と海外大学の産学連携のコミュニティ運営を担当。2020年にはFabCafe Kyotoのレジデンスプログラム「COUNTERPOINT」の立ち上げと運営に従事。また、FabCafeのグローバルネットワークの活動の言語化や他拠点連携の土壌醸成にも奔走中。2022年からは、自然のアンコントローラビリティを探究するコミュニティ「SPCS」の立ち上げと企画運営を担当。大学で学んだ社会保障やデンマークのフォルケホイスコーレ、イスラエルのキブツでの生活、そして、かつて料理家の森本桃世さんと共催していた発酵部活などが原体験となって、場の中にカオスをつくることに興味がある。